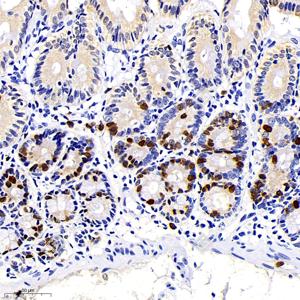
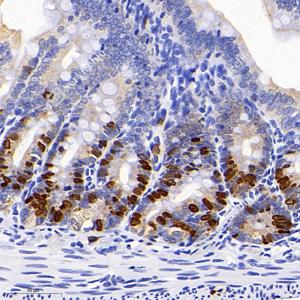

Anti-BrdU Mouse mAb
- 100 μL
产品信息
蛋白质全称 | 溴脱氧尿嘧啶核苷 |
别名 | Bromodeoxyuridine, Bromodeoxyuridine,5-Bromo-2′-deoxyuridine; 5-BrdU, Proliferation Marker; 5-Bromo-2-deoxyUridine |
免疫原 | KLH偶联的小鼠BrdU合成肽 |
抗体亚型 | IgG1, κ |
克隆号 | 4B6C12 |
纯化方式 | 亲和纯化 |
亚细胞定位 | 细胞核 |
应用
| 应用 | 物种 | 稀释 | 阳性样品 |
| IHC/IF 免疫组织化学/免疫荧光 | Species independent | 1: 100-1: 500 | 空肠, 新生小鼠的大脑 |
背景
Bromodeoxyuridine (5-bromo-2'-deoxyuridine, BrdU, BUdR, BrdUrd) is a synthetic nucleoside that is an analog of thymidine. It can be incorporated into the newly synthesized DNA of replicating cells (during the S phase of the cell cycle), substituting for thymidine during DNA replication. As such, BrdU is used for birth dating and monitoring cell proliferation. BrdU is a toxic and mutagenic substance. It triggers cell death, the formation of teratomas, alters DNA stability, lengthens the cell cycle, and has mitogenic, transcriptional and translational effects on cells that incorporate it.
图像
| IHC检测BrdU蛋白(货号 GB12051). 样品: 小鼠空肠, 4%多聚甲醛 (货号G1101) 固定12-24小时. 抗原修复: 用纯水配制2摩尔/升盐酸, 37℃处理30分钟使DNA变性. —抗: 1: 500稀释, 4℃ 孵育过夜. 二抗: HRP标记山羊抗小鼠IgG (H+L) (货号GB23301), 1: 200稀释, 室温孵育1小时. |
| IHC检测BrdU蛋白(货号 GB12051). 样品: 小鼠空肠, 4%多聚甲醛 (货号G1101) 固定12-24小时. 抗原修复: 用纯水配制2摩尔/升盐酸, 37℃处理30分钟使DNA变性. —抗: 1: 500稀释, 4℃ 孵育过夜. 二抗: HRP标记山羊抗小鼠IgG (H+L) (货号GB23301), 1: 200稀释, 室温孵育1小时. |
| IF检测BrdU蛋白(货号 GB12051)(红色). 样品: 小鼠新生小鼠脑, 4%多聚甲醛 (货号G1101) 固定12-24小时. 抗原修复: 用纯水配制2摩尔/升盐酸,37℃处理30分钟使DNA变性. 封闭: 3% BSA(货号GC305010)的PBS溶液, 室温孵育30分钟. —抗: 1: 500稀释, 4℃ 孵育过夜. 二抗: Cy3标记山羊抗小鼠IgG (H+L) (货号GB21301), 1: 300稀释, 室温孵育1小时. |
储存
| 储存条件 | 在-20℃下储存一年, 避免反复冻融. |
| 储存缓冲液 | 含0.15% ProClin300防腐剂, 100 μg/mL牛血清白蛋白和50%甘油的磷酸盐缓冲液. |
注意:
1.本产品仅供研究使用.
2.建议用一抗稀释液(G2025)稀释本产品.
| 货号 | 名称 | 规格 | 价格 | 操作 |
|---|
| 货号 | 名称 | 规格 | 价格 | 操作 |
|---|